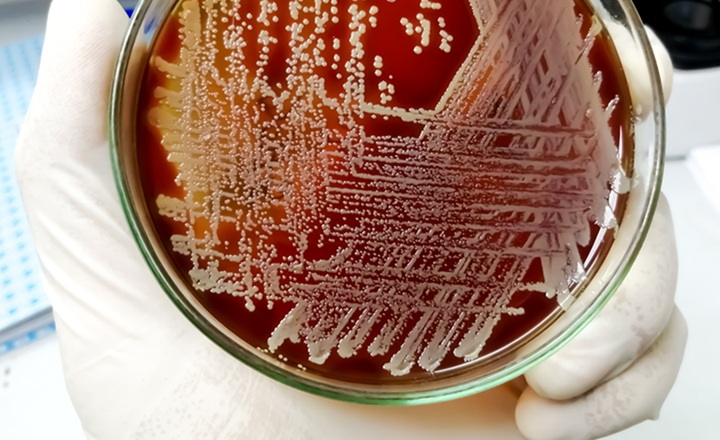
Faster AST reporting equals better outcomes

- Delayed AST delays targeted therapy: Conventional microbiology workflows can delay susceptibility results, prolonging empiric broad-spectrum therapy in sepsis and BSI.
- Broad-spectrum overuse: Excess carbapenem use accelerates antimicrobial resistance and increases healthcare costs.
- Laboratory workflow influences outcomes: Optimizing reporting practices and AST coverage can directly impact antimicrobial stewardship and patient outcomes.
- Economic implications: Faster microbiology reporting may shorten hospital stays and reduce antibiotic expenditures.
Key Findings: Yue et al. evaluated the effects of laboratory workflow interventions at a tertiary hospital, comparing bloodstream infection (BSI) cases (125 pre-implementation and 131 post-implementation) before and after implementation of a faster anti-microbial sensitivity testing (AST) reporting system.¹
- Faster diagnostic reporting: Median time to microbial identification decreased from 74.35 hours to 41.26 hours, and AST reporting time decreased from 74.35 hours to 56.02 hours.
- Earlier antibiotic optimization: Antibiotic regimen modifications occurred ~36 hours earlier within the first 72 hours of treatment.
- Carbapenem stewardship: Carbapenems showed the most MIC-driven therapy changes (20 additions and 10 discontinuations), reflecting improved targeted therapy following expanded AST reporting.
- Clinical and economic outcomes: Post-intervention patients experienced shorter hospital stays, lower antibiotic and testing costs (all P-values < 0.05). Additionally, a numerical trend toward lower mortality was observed in the post-intervention group, suggesting a potential clinical benefit that did not reach statistical significance.
Bigger Picture: This study highlights how microbiology laboratory workflow changes—not just new diagnostic technologies—can significantly influence clinical outcomes in bloodstream infections. By accelerating AST reporting and expanding antimicrobial coverage through dual testing cards, clinicians can adjust therapy earlier, reduce unnecessary broad-spectrum antibiotic exposure, and lower healthcare costs. The findings reinforce the role of integrated diagnostic optimization and antimicrobial stewardship programs in improving both patient outcomes and hospital economics, particularly in high-risk infections such as sepsis and bacteremia.
(Image Credit: iStock/ Md Saiful Islam Khan)